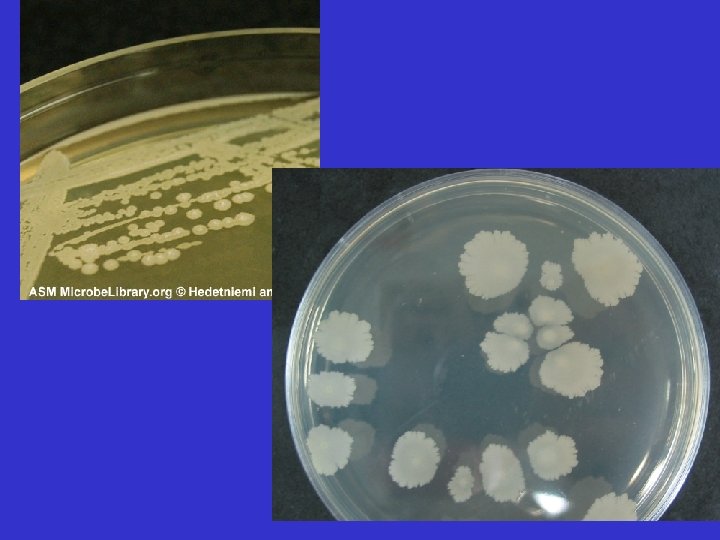

SBM 2044 Lecture 8 Bacillus and Corynebacterium Bacillus

SBM 2044 Lecture 8 Bacillus and Corynebacterium

Bacillus AIMS: • To provide an overview of Bacillus species • To introduce the anthrax disease • To explain the pathogenesis of B. anthracis, including the mechanisms of the secreted toxins

Bacillus • Aerobic, G+ rods in chains, spores are located in center of the non-motile bacilli • Found in soil, water, air and vegetation • Spores are viable for decades. • B. cereus – produce enterotoxin and cause food poisoning. • B. anthracis – infection in human through injured skin (cutaneous anthrax), mucous membranes (GI anthrax), or inhalation of spores into lung.

Spores • • Why do bacteria produce spores? Survival Classification Definition = a resting cell, highly resistant to dessication, heat, and chemical agents; when returned to favourable conditions bacteria re-activated, the spores germinate to produce single vegetative cells.

Bacillus anthracis

Anthrax • Primarily a disease of herbivores • In animals, portal of entry is through ingestion of spores: – Injured skin (cutaneous anthrax) – Mucous membranes (gastrointestinal anthrax) – Inhalation of spores into the lung (inhalation anthrax) • Spores germinate, and growth of vegetative organisms result in formation of a gelatinous oedema and congestion. • Spread via lymphatics to bloodstream and multiply freely in blood and tissues.

Typical anthrax lesion on arm at 10 th day.

Bacillus anthracis • Capsulated, poly-D-glutamic acid capsule is antiphagocytic • Anthrax toxin is made up of three proteins: – protective antigen (PA) – oedema factor (EF) – lethal factor (LF). • PA binds to specific host cell receptors and forms membrane channel that mediate entry of EF and LF into the cytosol. • EF is an adenylate cyclase – EF sustains the activation of host c. AMP-dependent signalling pathways. • LF is a metalloproteinase that site-specifically cleaves MKKs (mitogen-activated protein kinases). – cleavage of MKKs by LF prevents them from activating their downstream MAPK (mitogen-activated protein kinase) substrates and subsequently the cell is unable to respond to any stimuli. • http: //www. sumanasinc. com/webcontent/anisamples/microbiology/ani_anthrax. swf

Bacillus • Anthrax can be successfully treated with antibiotics if they are administered prophylactically after spore exposure. • Treatment: ciprofloxacin, penicillin G along with gentamicin and streptomycin. Also fluoroquinolones and tetracyclines. • Vaccine with live spores and a toxoid used to protect livestock in endemic areas.

SBM 2044: Lecture 8 Diphtheria AIMS: • To discuss diphtheria in detail - paradigm of: - an early success in microbiology - first toxoid vaccine - approaches used to study a bacterial protein toxin

Diphtheria • Acute, transmissible, infection of upper respiratory tract - mostly in children aged 2 - 9 • Caused by Corynebacterium diphtheriae - Gram-positive, aerobic, non-motile, ‘club-shaped’ rod Black colonies on tellurite medium ‘Halos’ on Tinsdale’s medium


Diphtheria Inflammatory exudate ‘pseudomembranous’ appearance Bullneck diphtheria

Milestones in Microbiology Loeffler (1884) – isolated C. diphtheriae • pure culture virulent in animals • C. diphtheriae localised, but lesions at other sites suggested bacteria might release a “poison” Roux & Yersin (1888) Confirmed lesions due to a TOXIN

Diphtheria – key early success in Microbiology von Behring & colleagues (1890 s) C. diphtheriae culture filtrates treated with iodine tri-chloride induced specific immunity in animals + immunity could be passively transferred in blood to other animals First TOXOID vaccine By 1920 s Diphtheria toxoid vaccine widely available in USA (Later included as part of the triple DPT vaccine)

Current incidence of diphtheria Endemic in many economically-deprived countries that cannot afford widespread vaccination Very rare in developed countries (e. g. 0 -2 cases/year in US) (e. g. contrast with 1921: >200, 000 cases in USA) Nevertheless - no room for complacency. Potential dangers illustrated by resurgence of diphtheria in Russia during early 1990 s.

Reported Russian cases of diphtheria between 1965 - 1994 • Resurgence occurred despite high vaccine uptake (> 90% children) 50, 000 40, 000 • High proportion of cases in young adults 30, 000 20, 000 10, 000 65 72 81 Year 90 94

Reasons for resurgence? • Inadequate vaccination of children in ‘ 70’s ? ? - strongly denied - no increase in children in 1970 s • More subtle explanation ? Insufficient data to provide clear answer, but good example of how even long-controlled diseases can re-emerge to cause serious problems In Russia, aggressive efforts to boost anti-toxin immunity by vaccination of adults since 1994 worked - cases began to decrease in 1995

Diphtheria Toxin Another key early finding 1959: First observed that addition of DTx to cultured cells inhibits protein synthesis But, further advance had to await more effective techniques for e. g. protein purification & analysis.

Exotoxins • Exotoxins usually secretedy by the bacterium by the Type I or Type II secretion system • Exotoxins are synthesised as protoxins and must be activated on binding to host cell membrane. • Activation involves a proteolytic cleavage and reduction of a disulphide bond (that holds A + B domains together). • Please read Chapter 9 Schaechter’s

Late 1960 s + 1970 s: Biochemical studies on DTx purified: Toxicity greatly increased by ‘nicking’ intact toxin with trypsin (a protease) SDS-PAGE Intact - low activity Mr 58 K single polypeptide N- ‘nicked’ - high activity linked A + B fragments A (21 K) Ns s -C B (37 K) s s -C -C s s -N

disulphide bonds X-S-S-X oxidation A (21 K) N- B (37 K) reduction s s X-SH + HS-X -C s s -N -C Reduction Purified individual A and B fragments Compared each with intact ‘nicked’ toxin NN- A (21 K) B (37 K) -C -C

Comparing linked A + B with purified A or B alone Toxicity Inhibition of protein synthesis intact cells cell extracts A+B A B Conclusions: • DTx kills cells by inhibiting protein synthesis • Inhibitory activity resides in fragment A, but first A must separate from B • Possible that Fragment B ‘delivers’ A to cell cytoplasm

DTx Entry Early observations (1960 s): • Lag of 20 – 30 min between binding and killing suggests involvement of entry ‘pathway’ • NH 4 Cl protected cells against DTx suggests involved of an acidic compartment Late 1970 s • Discovery of RME (receptor-mediated endocytosis) via clatherin-coated pits and acidification of endocytic vesicles Involved in DTx entry ? ?

RME

Clathrin-coated vesicles

Inside the host cell • Once inside the endosomal vesicle, reduction of disulphide bond takes place and separates A from B • Acidic conditions in vesicle promotes translocation of A domain into cytosol • A domain ADP ribosylates elongation factor-2 (EF-2), hence blocks protein synthesis • EF-2 the only known substrate for DTx – due to its specific modified histidine residues (called ‘diphthamide’) • http: //www. sumanasinc. com/webcontent/animations/co ntent/diphtheria. html

Early 1980 s Possible involvement of RME supported by additional circumstantial evidence suggesting ‘productive’ DTx entry facilitated by a low p. H. Example: Cells in buffer p. H 7. 0 p. H 5. 5 Lag between DTx binding and killing 20 -30 min < 5 min DTx-A could cross cell membrane directly at low p. H

Other ‘ADP-ribosyl transferase’ A-B subunit toxins Pathogen Toxin C. diphtheriae Diphtheria Pseudomonas aeruginosa Exotoxin A (ETA) Vibrio cholerae Cholera E. coli (ETEC) Heat-labile (LT) Bordetella pertussis Pertussis Clostridium perfringens iota-toxin Several sp. of Clostridium iota-like Target EF-2 Gia Gsa Actin Effect inhibit protein synthesis increase c. AMP production Destroy actin filaments
- Slides: 30